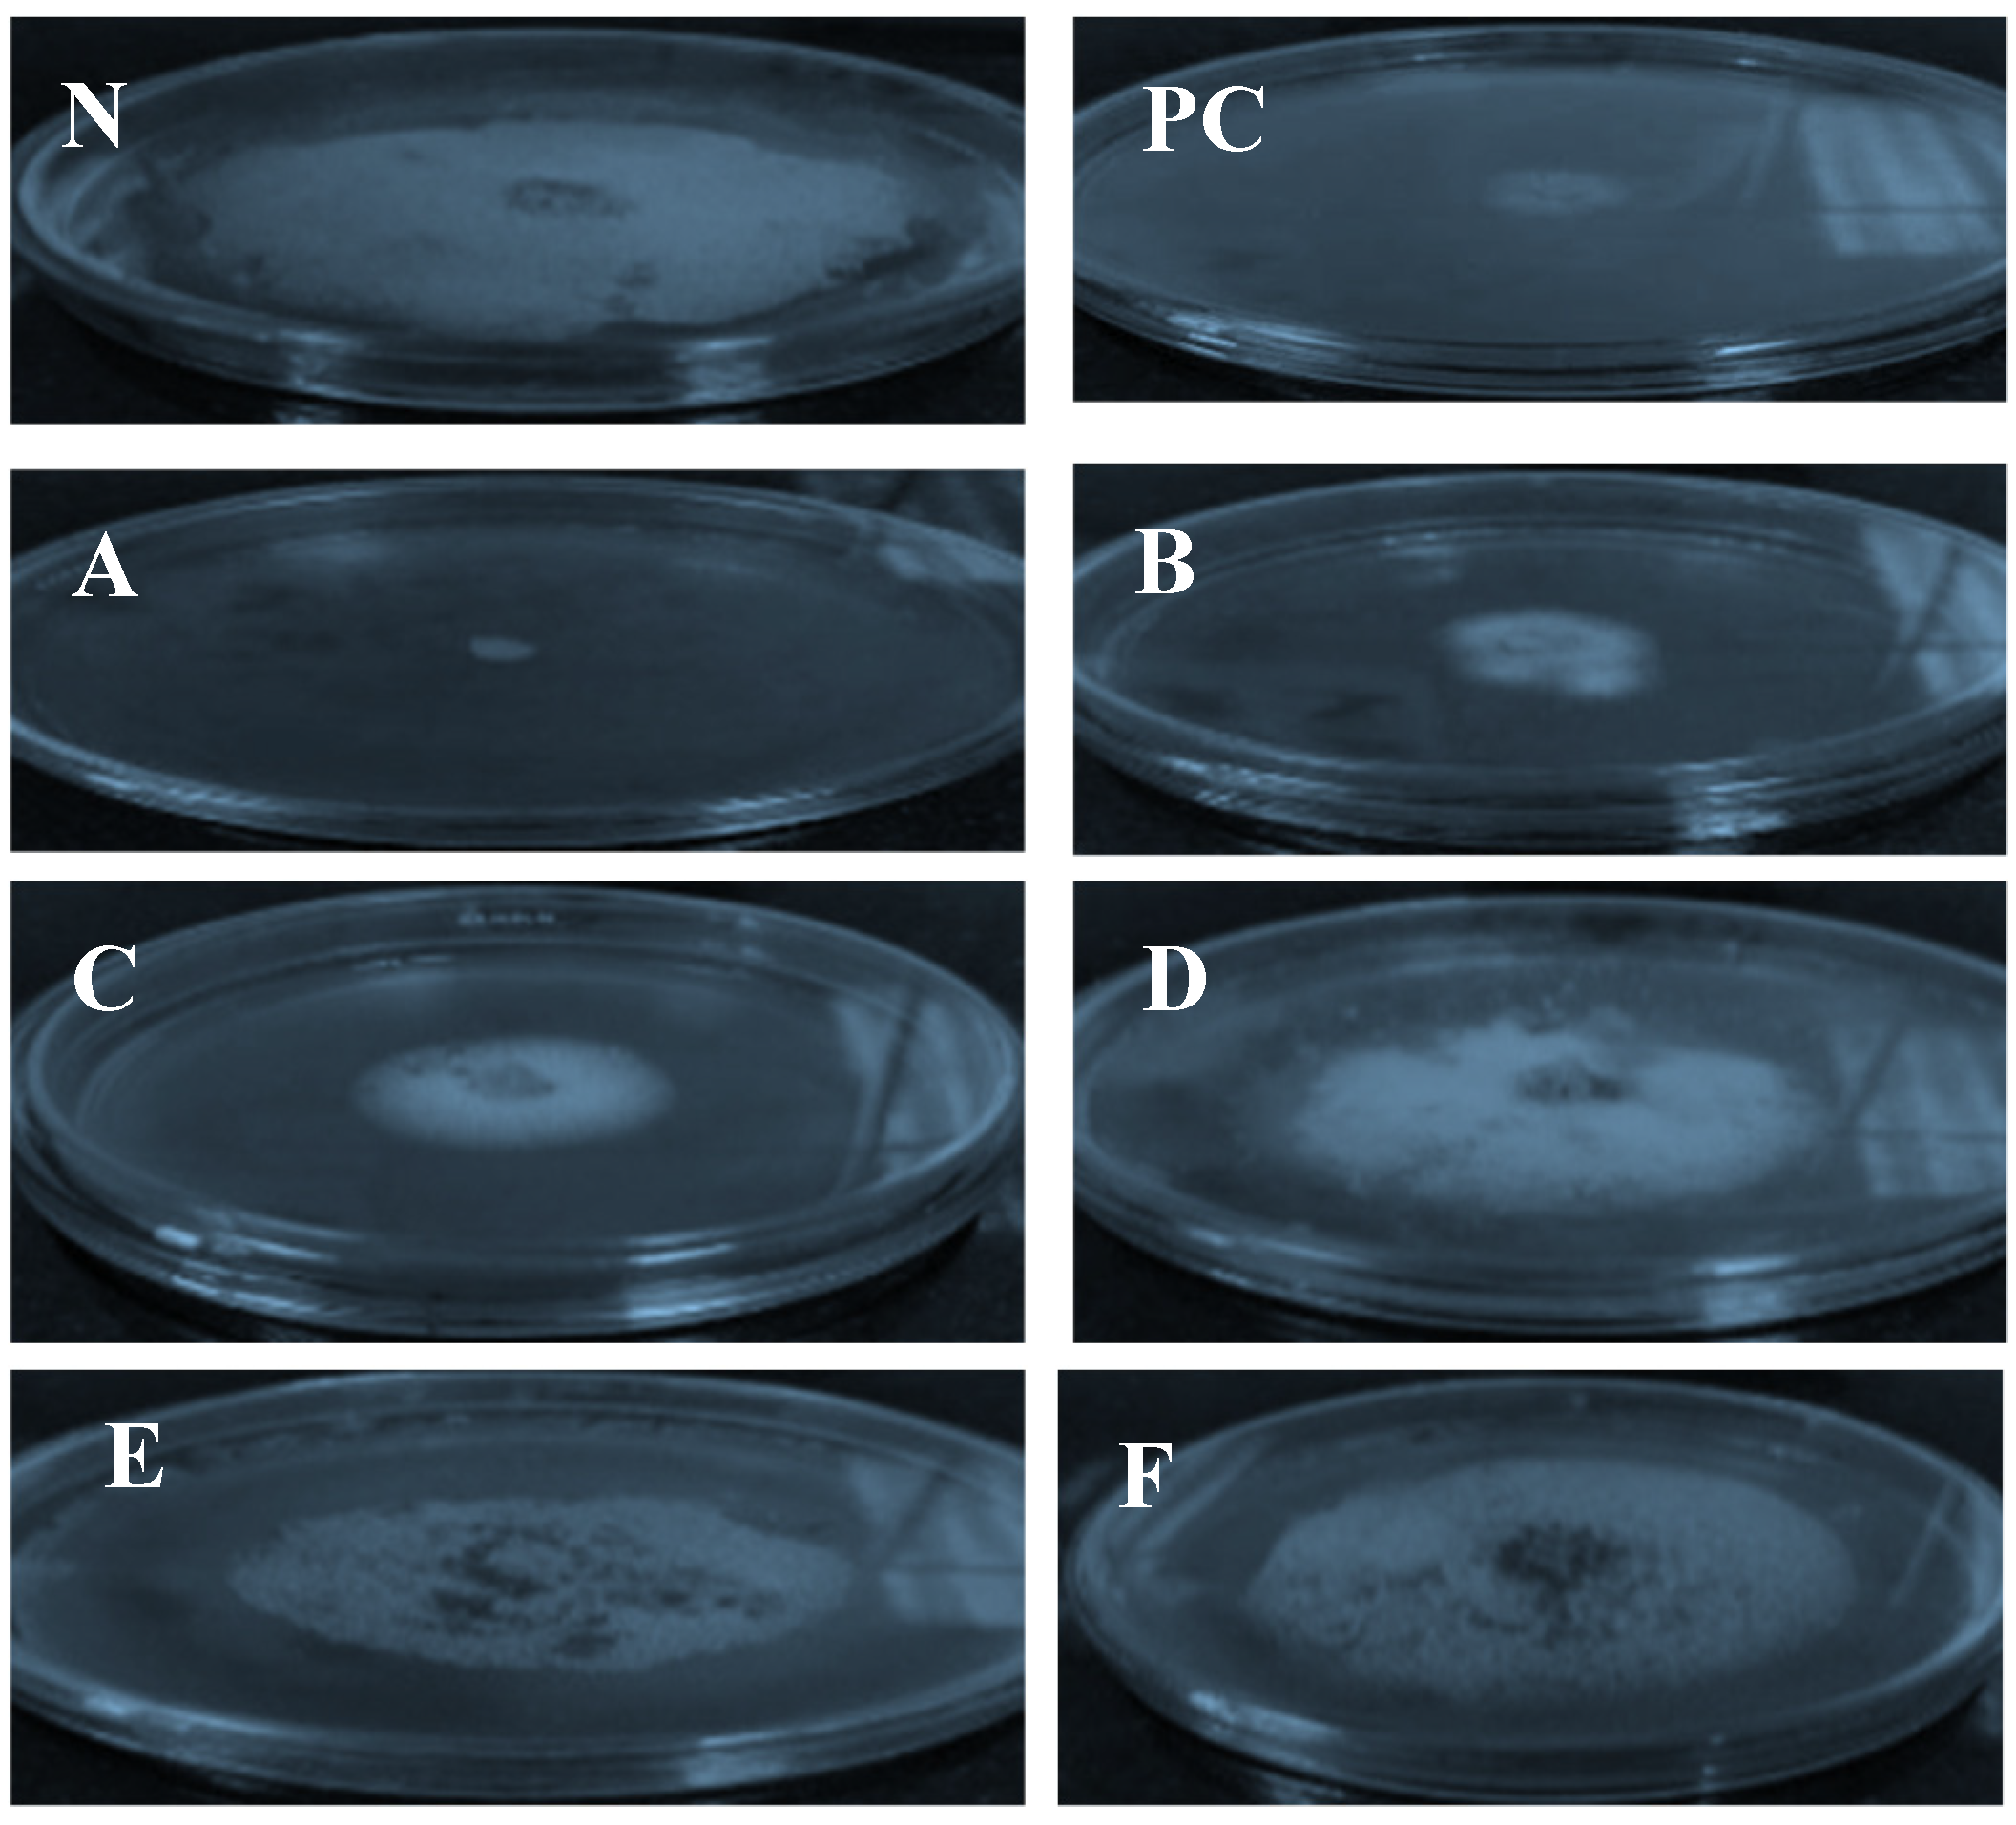
Molecules 26 06118 g003

Antifungal Evaluation and Molecular Docking Studies of Olea europaea Leaf Extract, Thymus vulgaris and Boswellia carteri Essential Oil as Prospective Fungal Inhibitor Candidates
Abstract
:1. Introduction
2. Results
2.1. Morphological Characterization, Isolation, and Pathogenicity Tests
2.2. Molecular Characterization and Phylogenetic Tree of the Purified F. oxysporum Isolate
2.3. Biological Activity
2.4. GC-MS Analysis
2.5. Effects of Plant Phytochemical Extracts on the Virulence Proteins of F. oxysporum According to Docking Analysis
3. Discussion
4. Materials and Methods
4.1. Morphological Characterization and Isolation of Fusarium oxysporum f. sp. lactucae
4.2. Pathogenicity Test
4.3. Molecular Identification of Fusarium oxysporum Isolates
4.3.1. Genomic Extraction from Fungal DNA
4.3.2. Identification of F. oxysporum Isolate through ITS Gene Sequencing
4.3.3. Sequencing and Bioinformatic Analyses
4.4. Plant Extract Preparation
4.4.1. Materials
- All solvents used were of LC/MS grade and were purchased from J. T. Baker (The Netherlands).
- All other chemicals and standards were purchased from Sigma Aldrich (St. Louis, MO, USA).
4.4.2. Preparation of O. europaea Leaf Extracts
4.4.3. Preparation of Essential Oil (Thymus vulgaris)
4.5. Antifungal Activity of Plant Extracts and Essential Oils In Vitro
4.6. GC/MS Analysis of Essential Oil (Thymus vulgaris)
Sample Sialylation for GC/MS Analysis
4.7. Molecular Docking Analysis
4.8. Statistical Data Interpretation
5. Conclusions
Author Contributions
Funding
Institutional Review Board Statement
Informed Consent Statement
Data Availability Statement
Acknowledgments
Conflicts of Interest
Sample Availability
References
- Singh, R.J.; Lebeda, A.; Ryder, E.; Grube, R.; Dolezalová, I.; KrÍstková, E. Lettuce (Asteraceae; Lactuca spp.). Veg. Crops 2006, 3, 377–472. [Google Scholar] [CrossRef]
- Mulabagal, V.; Ngouajio, M.; Nair, A.; Zhang, Y.; Gottumukkala, A.L.; Nair, M.G. In vitro evaluation of red and green lettuce (Lactuca sativa) for functional food properties. Food Chem. 2010, 118, 300–306. [Google Scholar] [CrossRef]
- Matheron, M.E.; Gullino, M.L. Fusarium wilts of lettuce and other salad crops. In Fusarium Wilts of Greenhouse Vegetable and Ornamental Crops; Gullino, M.L., Katan, J., Garibaldi, A., Eds.; APS Press: St. Paul, MN, USA, 2012; pp. 175–183. [Google Scholar]
- Gilardi, G.; Ortega, S.F.; Van Rijswick, P.C.J.; Ortu, G.; Gullino, M.L.; Garibaldi, A. A new race of Fusarium oxysporum f. sp. lactucae of lettuce. Plant Pathol. 2016, 66, 677–688. [Google Scholar] [CrossRef]
- Gordon, T.R. Fusarium oxysporum and the Fusarium Wilt Syndrome. Annu. Rev. Phytopathol. 2017, 55, 23–39. [Google Scholar] [CrossRef]
- Feliziani, E.; Romanazzi, G. Preharvest application of synthetic fungicides and alternative treatments to control postharvest decay of fruit. Stewart Postharvest Rev. 2013, 9, 1–6. [Google Scholar]
- Lichtenstein, E.P. Insecticides Occurring Naturally in Crops. Adv. Chem. 1966, 1, 34–38. [Google Scholar] [CrossRef]
- Turek, C.; Stintzing, F.C. Stability of Essential Oils: A Review. Compr. Rev. Food Sci. Food Saf. 2013, 12, 40–53. [Google Scholar] [CrossRef]
- Raveau, R.; Fontaine, J.; Sahraoui, A.L.-H. Essential Oils as Potential Alternative Biocontrol Products against Plant Pathogens and Weeds: A Review. Foods 2020, 9, 365. [Google Scholar] [CrossRef] [PubMed]
- Ahmad, A.; Khan, A.; Yousuf, S.; Khan, L.A.; Manzoor, N. Proton translocating ATPase mediated fungicidal activity of eugenol and thymol. Fitoterapia 2010, 81, 1157–1162. [Google Scholar] [CrossRef]
- Friedman, M. Overview of antibacterial, antitoxin, antiviral, and antifungal activities of tea flavonoids and teas. Mol. Nutr. Food Res. 2007, 51, 116–134. [Google Scholar] [CrossRef] [PubMed]
- Lee-Huang, S.; Huang, P.L.; Zhang, D.; Lee, J.W.; Bao, J.; Sun, Y.; Chang, Y.-T.; Zhang, J.; Huang, P. Discovery of small-molecule HIV-1 fusion and integrase inhibitors oleuropein and hydroxytyrosol: Part I. Integrase inhibition. Biochem. Biophys. Res. Commun. 2007, 354, 872–878. [Google Scholar] [CrossRef] [PubMed]
- Soni, M.; Burdock, G.; Christian, M.; Bitler, C.; Crea, R. Safety assessment of aqueous olive pulp extract as an antioxidant or antimicrobial agent in foods. Food Chem. Toxicol. 2006, 44, 903–915. [Google Scholar] [CrossRef] [PubMed]
- Tian, J.; Huang, B.; Luo, X.; Zeng, H.; Ban, X.; He, J.; Wang, Y. The control of Aspergillus flavus with Cinnamomum jensenianum Hand.-Mazz essential oil and its potential use as a food preservative. Food Chem. 2012, 130, 520–527. [Google Scholar] [CrossRef]
- Prakash, B.; Kedia, A.; Mishra, P.K.; Dubey, N. Plant essential oils as food preservatives to control moulds, mycotoxin contamination and oxidative deterioration of agri-food commodities—Potentials and challenges. Food Control 2015, 47, 381–391. [Google Scholar] [CrossRef]
- Di Pietro, A.; García-Maceira, F.I.; Méglecz, E.; Roncero, M.I.G. A MAP kinase of the vascular wilt fungus Fusarium oxysporum is essential for root penetration and pathogenesis. Mol. Microbiol. 2004, 39, 1140–1152. [Google Scholar] [CrossRef]
- Rispail, N.; Soanes, D.M.; Ant, C.; Czajkowski, R.; Grünler, A.; Huguet, R.; Perez-Nadales, E.; Poli, A.; Sartorel, E.; Valiante, V.; et al. Comparative genomics of MAP kinase and calcium–calcineurin signalling components in plant and human pathogenic fungi. Fungal Genet. Biol. 2009, 46, 287–298. [Google Scholar] [CrossRef]
- Husaini, A.M.; Sakina, A.; Cambay, S.R. Host–Pathogen Interaction in Fusarium oxysporum Infections: Where Do We Stand? Mol. Plant-Microbe Interact. 2018, 31, 889–898. [Google Scholar] [CrossRef]
- Zhang, Y.; Ma, L.-J. Deciphering Pathogenicity of Fusarium oxysporum from a Phylogenomics Perspective. Adv. Genet. 2017, 100, 179–209. [Google Scholar] [CrossRef]
- O’Donnell, K.; Kistler, H.; Cigelnik, E.; Ploetz, R.C. Multiple evolutionary origins of the fungus causing Panama disease of banana: Concordant evidence from nuclear and mitochondrial gene genealogies. Proc. Natl. Acad. Sci. USA 1998, 95, 2044–2049. [Google Scholar] [CrossRef]
- Zarrin, M.; Ganj, F.; Faramarzi, S. Analysis of the rDNA internal transcribed spacer region of the Fusarium species by polymerase chain reaction-restriction fragment length polymorphism. Biomed. Rep. 2016, 4, 471–474. [Google Scholar] [CrossRef]
- Summerell, B.A.; Salleh, B.; Leslie, J.F. A Utilitarian Approach to Fusarium Identification. Plant. Dis. 2003, 87, 117–128. [Google Scholar] [CrossRef] [PubMed]
- Cabral, C.S.; Brunelli, K.R.; Costa, H.; De Noronha Fonseca, M.E.; Boiteux, L.S.; Reis, A. Identification of Fusarium oxysporum f. sp. lactucae race 1 as the causal agent of lettuce wilt in Brazil. Trop. Plant. Pathol. 2014, 39, 197–202. [Google Scholar] [CrossRef]
- Zorić, N.; Kopjar, N.; Kraljić, K.; Oršolić, N.; Tomić, S.; Kosalec, I. Olive leaf extract activity against Candida albicans and C. dubliniensis—The in vitro viability study. Acta Pharm. 2016, 66, 411–421. [Google Scholar] [CrossRef] [PubMed]
- Khan, A.A.; Amjad, M.S. Saboon GC-MS analysis and biological activities of Thymus vulgaris and Mentha arvensis essential oil. Turk. J. Biochem. 2019, 44, 388–396. [Google Scholar] [CrossRef]
- Mohsenipour, Z.; Hassanshahian, M. The inhibitory effect of Thymus vulgaris extracts on the planktonic form and biofilm structures of six human pathogenic bacteria. Avicenna J. Phytomed. 2015, 5, 309–318. [Google Scholar]
- Muzzalupo, I.; Badolati, G.; Chiappetta, A.; Picci, N.; Muzzalupo, R. In vitro Antifungal Activity of Olive (Olea europaea) Leaf Extracts Loaded in Chitosan Nanoparticles. Front. Bioeng. Biotechnol. 2020, 8, 151. [Google Scholar] [CrossRef] [PubMed]
- Sircar, B.; Mandal, S. Screening of Elaeocarpus floribundus fruit extracts for bioactive phytocomponents and antibacterial activity against food-borne bacteria. Int. J. Res. Med. Sci. 2017, 5, 3665–3671. [Google Scholar] [CrossRef]
- de Lira Mota, K.S.; de Oliveira Pereira, F.; De Oliveira, W.A.; Lima, I.O.; de Oliveira Lima, E. Antifungal Activity of Thymus vulgaris L. Essential Oil and Its Constituent Phytochemicals against Rhizopus oryzae: Interaction with Ergosterol. Molecules 2012, 17, 14418–14433. [Google Scholar] [CrossRef]
- Rota, C.; Carramiñana, J.J.; Burillo, J.; Herrera, A. In Vitro Antimicrobial Activity of Essential Oils from Aromatic Plants against Selected Foodborne Pathogens. J. Food Prot. 2004, 67, 1252–1256. [Google Scholar] [CrossRef]
- Zhang, J.; Ma, S.; Du, S.; Chen, S.; Sun, H. Antifungal activity of thymol and carvacrol against postharvest pathogens Botrytis cinerea. J. Food Sci. Technol. 2019, 56, 2611–2620. [Google Scholar] [CrossRef]
- Omar, H.S.; Elsayed, T.R.; Reyad, N.E.A.; Shamkh, I.M.; Sedeek, M.S. Gene-targeted molecular phylogeny, phytochemical analysis, antibacterial and antifungal activities of some medicinal plant species cultivated in Egypt. Phytochem. Anal. 2020, 32, 724–739. [Google Scholar] [CrossRef]
- Abdel-Kawy, M.A.; Michel, C.G.; Kirollos, F.N.; Hussien, R.A.A.; Al-Mahallawi, A.M.; Sedeek, M.S. Chemical composition and potentiation of insecticidal and fungicidal activities of Citrus trifoliata L. fruits essential oil against Spodoptera littoralis, Fusarium oxysporum and Fusarium solani via nano-cubosomes. Nat. Prod. Res. 2019, 35, 2438–2443. [Google Scholar] [CrossRef]
- Toubi, Y.; Abrigach, F.; Radi, S.; Souna, F.; Hakkou, A.; Alsayari, A.; Bin Muhsinah, A.; Mabkhot, Y.N. Synthesis, Antimicrobial Screening, Homology Modeling, and Molecular Docking Studies of a New Series of Schiff Base Derivatives as Prospective Fungal Inhibitor Candidates. Molecules 2019, 24, 3250. [Google Scholar] [CrossRef]
- Rampersad, S.N. Pathogenomics and Management of Fusarium Diseases in Plants. Pathogens 2020, 9, 340. [Google Scholar] [CrossRef] [PubMed]
- Nelson, P.E.; Toussoun, T.A.; Marasas, W.F.O. Fusarium Species. In An Illustrated Manual for Identification; Pennsylvania State University Press: University Park, PA, USA, 1983; p. 193. [Google Scholar]
- Leslie, J.F.; Summerell, B.A. The Fusarium Laboratory Manual; Blackwell Publishing: Hoboken, NJ, USA, 2006; pp. 1–2. [Google Scholar]
- Egyptian Pharmacopoeia. The English Text of Arab Republic of Egypt, 4th ed.; Central Adminstration and Pharmaceutical Affairs (CAPA); Ministry of Health and Population: Cairo, Egypt, 2005; pp. 31–33.
- Gupta, P.; Khare, V.; Kumar, D.; Ahmad, A.; Banerjee, G.; Singh, M. Comparative evaluation of disc diffusion and E-test with broth micro-dilution in sus-ceptibility testing of amphotericin B, voriconazole and caspofungin against clinical Aspergillus isolates. J. Clin. Diagn. Res. 2015, 9, DC04. [Google Scholar] [PubMed]
- Farag, M.A.; Rasheed, D.; Kamal, I.M. Volatiles and primary metabolites profiling in two Hibiscus sabdariffa (roselle) cultivars via headspace SPME—GC-MS and chemometrics. Food Res. Int. 2015, 78, 327–335. [Google Scholar] [CrossRef] [PubMed]
- Waller, W.M.; Duncan, D.B. A bayes rule for symmetric multiple composition problem. J. Am. Stat. Assoc. 1969, 64, 1487–1503. [Google Scholar]

| Plant Extract | IC50 (mg/mL) |
|---|---|
| Thyme oil | 28.99 (µL/ml) |
| Ethanol extract | 49.60 |
| Dichloromethane extract | 32.51 |
| Chloroform extract | 31.35 |
| Ethyl acetate extract | 521.9 |
| B. carteri | 176.2 |
| Compound No. | RI | Identified Compound | MWT | %Similarity | Chemical Class | Area% |
|---|---|---|---|---|---|---|
| 1 | 788 | 1,2-Bis(trimethylsiloxy)ethane | 206 | 75 | Alkane | 1.3 |
| 2 | 905 | Ethanimidic acid, N-(trimethylsilyl)-, trimethylsilyl ester | 203 | 93 | Acid | 2.2 |
| 3 | 915 | Propanoic acid, 2-[(trimethylsilyl)oxy]-, trimethylsilyl ester | 234 | 96 | Acid | 1.8 |
| 4 | 1078 | Butanoic acid, 4-[(trimethylsilyl)oxy]-, trimethylsilyl ester | 248 | 89 | Acid | 1.6 |
| 5 | 1086 | Cyclohexanone, 3,3,5-trimethyl- | 140 | 77 | Ketone | 0.4 |
| 6 | 1108 | Glycerol, 3TMS derivative | 308 | 96 | Alcohol | 6.9 |
| 7 | 1163 | Picolinic acid, TMS derivative | 195 | 95 | Acid | 2.2 |
| 8 | 1192 | Octanoic acid, trimethylsilyl ester | 216 | 75 | Fatty acid | 0.2 |
| 9 | 1252 | 2-(2-Butoxyethoxy)ethoxy-trimethylsilane | 254 | 98 | Alcohol | 0.9 |
| 10 | 1338 | 3,6,9,12-Tetraoxa-2,13-disilatetradecane, 2,2,13,13-tetramethyl- | 294 | 70 | Alcohol | 0.4 |
| 11 | 1406 | Octanoic acid, TBDMS | 258 | 76 | Fatty acid | 0.2 |
| 12 | 1612 | Hexadecane | 226 | 95 | Alkane | 0.4 |
| 13 | 1664 | 8,10-Dioxaheptadecane | 244 | 87 | Alkane | 3.8 |
| 14 | 1685 | L-Proline, 2TBDMS derivative | 343 | 73 | Amino acid | 0.9 |
| 15 | 1699 | L-Leucine, 2TBDMS derivative | 359 | 87 | Amino acid | 3.6 |
| 16 | 1699 | Isoleucine, 2TBDMS derivative | 359 | 89 | Amino acid | 1.3 |
| 17 | 1769 | Myristic acid | 228 | 93 | Fatty acid | 0.4 |
| 1788 | Tetradecanoic acid, trimethylsilyl ester | 300 | 85 | Fatty acid | 0.4 | |
| 19 | 1878 | Hexadecenoic acid, methyl ester | 270 | 87 | Fatty acid | 0.7 |
| 20 | 1916 | Mandelic acid di(tert-butyldimethylsilyl)- | 380 | 91 | Acid | 3.4 |
| 21 | 1968 | Palmitic acid | 256 | 92 | Fatty acid | 11.6 |
| 22 | 1987 | Hexadecenoic acid, trimethylsilyl ester | 328 | 77 | Fatty acid | 5.8 |
| 23 | 2009 | Eicosane | 282 | 97 | Alkane | 0.4 |
| 24 | 2037 | α.-D-(+)-Talopyranose, pentakis(trimethylsilyl) ether | 540 | 85 | Sugar | 0.4 |
| 25 | 2066 | Trimethylsilyl ether of glucitol | 614 | 70 | Sugar | 1.6 |
| 26 | 2081 | 7,9-Di-tert-butyl-1-oxaspiro(4,5)deca-6,9-diene-2,8-dione | 276 | 88 | Lactone | 0.9 |
| 27 | 2186 | Octadecanoic acid, trimethylsilyl ester | 356 | 85 | Fatty acid | 3.8 |
| 28 | 2194 | Oleic acid, trimethylsilyl ester | 354 | 86 | Fatty acid | 2.5 |
| 29 | 2581 | Hexadecanoic acid, 2,3-bis[(trimethylsilyl)oxy]propyl ester | 474 | 94 | Fatty acid | 1.3 |
| 30 | 2780 | Glycerol monostearate, 2TMS derivative | 502 | 85 | Alcohol | 0.4 |
| 31 | 2789 | β.-Sitosterol trimethylsilyl ether | 486 | 87 | Sterol | 1.1 |
| 32 | 2900 | Nonacosane | 408 | 95 | Alkane | 0.4 |
| 33 | 2914 | Squalene | 410 | 86 | Organic compound | 0.4 |
| 34 | 2931 | α.-Amyrin, TMS derivative | 498 | 96 | Triterpene | 0.9 |
| 35 | 3343 | Spirosol-5-en-3-ol, 28-acetyl-, acetate, (3.β.,22.α.,25R)- | 497 | 97 | Alcohol | 7.2 |
| 36 | 3401 | Tetratriacontane | 478 | 95 | Alkane | 1.6 |
| 37 | 3410 | Stigmasta-3,5-dien-7-one | 410 | 85 | Sterol | 0.7 |
| 38 | 3600 | Hexatriacontane | 506 | 95 | Alkane | 3.8 |
| 39 | 3986 | Propanoic acid, 3,3′-thiobis-, ditetradecyl ester | 570 | 70 | Acid | 2.7 |
| Compound No. | RI | Identified Compound | Chemical Class | MWT | %Similarity | Area% |
|---|---|---|---|---|---|---|
| 1 | 788 | 1,2-Bis(trimethylsiloxy)ethane | Alkane | 206 | 84 | 0.9 |
| 2 | 905 | Ethanimidic acid, N-(trimethylsilyl)-, trimethylsilyl ester | Acid | 203 | 95 | 1.2 |
| 3 | 915 | Propanoic acid, 2-[(trimethylsilyl)oxy]-, trimethylsilyl ester | Acid | 234 | 95 | 0.5 |
| 4 | 993 | Hexanoic acid, TMS derivative | Acid | 188 | 78 | 0.7 |
| 5 | 1078 | Butanoic acid, 4-[(trimethylsilyl)oxy]-, trimethylsilyl ester | acid | 248 | 89 | 1.4 |
| 6 | 1086 | Cyclohexanone, 3,3,5-trimethyl- | Ketone | 140 | 75 | 0.2 |
| 7 | 1108 | Glycerol, 3TMS derivative | Alcohol | 308 | 95 | 7.3 |
| 8 | 1163 | Picolinic acid, TMS derivative | Acid | 195 | 96 | 2.1 |
| 9 | 1192 | Octanoic acid, trimethylsilyl ester | Fatty acid | 216 | 73 | 0.2 |
| 10 | 1252 | 2-(2-Butoxyethoxy)ethoxy-trimethylsilane | Alcohol | 254 | 97 | 0.9 |
| 11 | 1338 | 3,6,9,12-Tetraoxa-2,13-disilatetradecane, 2,2,13,13-tetramethyl- | Alcohol | 294 | 70 | 0.2 |
| 12 | 1406 | Octanoic acid, TBDMS | Fatty acid | 258 | 72 | 0.2 |
| 13 | 1437 | 3,6,10,13-Tetraoxa-2,14-disilapentadecane, 2,2,14,14-tetramethyl- | Alcohol | 308 | 70 | 0.2 |
| 14 | 1585 | Quinoline | Alkaloid | 197 | 73 | 0.7 |
| 15 | 1612 | Hexadecane | alkane | 226 | 70 | 0.5 |
| 16 | 1664 | 8,10-Dioxaheptadecane | Alkane | 244 | 89 | 3.1 |
| 17 | 1682 | Hexadecane, 7,9-dimethyl- | Alkane | 254 | 90 | 0.2 |
| 18 | 1685 | L-Proline, 2TBDMS derivative | Amino acid | 343 | 71 | 0.7 |
| 19 | 1692 | β.-D-(+)-Xylopyranose, 4TMS derivative | Sugar | 438 | 86 | 0.2 |
| 20 | 1699 | L-Leucine, 2TBDMS derivative | Amino acid | 359 | 90 | 0.9 |
| 21 | 1699 | Isoleucine, 2TBDMS derivative | Amino acid | 359 | 88 | 0.2 |
| 22 | 1766 | Sebacic acid, 2TMS derivative | Acid | 346 | 80 | 0.9 |
| 23 | 1769 | Myristic acid | Fatty acid | 228 | 92 | 0.2 |
| 24 | 1788 | Tetradecanoic acid, trimethylsilyl ester | Fatty acid | 300 | 76 | 0.9 |
| 25 | 1878 | Hexadecanoic acid, methyl ester | Fatty acid | 270 | 94 | 0.5 |
| 26 | 1888 | n-Pentadecanoic acid, trimethylsilyl ester | Fatty acid | 314 | 85 | 0.5 |
| 27 | 1916 | Mandelic acid di(tert-butyldimethylsilyl)- | Acid | 380 | 94 | 2.8 |
| 28 | 1968 | Palmitic acid | Fatty acid | 256 | 92 | 9.2 |
| 29 | 1987 | Hexadecanoic acid, trimethylsilyl ester | Fatty acid | 328 | 80 | 8.5 |
| 30 | 2009 | Eicosane | Alkane | 282 | 96 | 0.2 |
| 31 | 2037 | α.-D-(+)-Talopyranose, pentakis(trimethylsilyl) ether | Sugar | 540 | 87 | 0.7 |
| 32 | 2066 | Trimethylsilyl ether of glucitol | Sugar | 614 | 92 | 1.9 |
| 33 | 2067 | Heptadecanoic acid | Fatty acid | 270 | 75 | 0.9 |
| 34 | 2081 | 7,9-Di-tert-butyl-1-oxaspiro(4,5)deca-6,9-diene-2,8-dione | Lactone | 276 | 90 | 0.5 |
| 35 | 2087 | Heptadecanoic acid, TMS derivative | Fatty acid | 342 | 85 | 0.5 |
| 36 | 2186 | Octadecanoic acid, trimethylsilyl ester | Fatty acid | 356 | 75 | 5.0 |
| 37 | 2194 | Oleic acid, trimethylsilyl ester | Fatty acid | 354 | 75 | 5.2 |
| 38 | 2210 | α.-Linolenic acid, TMS derivative | Fatty acid | 350 | 90 | 0.2 |
| 39 | 2581 | Hexadecanoic acid, 2,3-bis[(trimethylsilyl)oxy]propyl ester | Fatty acid | 474 | 85 | 2.8 |
| 40 | 2780 | Glycerol monostearate, 2TMS derivative | Alcohol | 502 | 87 | 0.5 |
| 41 | 2788 | 1-Monooleoylglycerol, 2TMS derivative | Alcohol | 500 | 70 | 0.2 |
| 42 | 2789 | β.-Sitosterol trimethylsilyl ether | Sterol | 486 | 71 | 1.2 |
| 43 | 2796 | 1-Monolinolein, 2TMS derivative | Fatty acid | 498 | 91 | 14.2 |
| 44 | 2900 | Nonacosane | Alkane | 408 | 89 | 0.2 |
| 45 | 2914 | Squalene | Organic compound | 410 | 95 | 0.5 |
| 46 | 2931 | α.-Amyrin, TMS derivative | Triterpene | 498 | 96 | 1.2 |
| 47 | 2955 | Ergometrinine, 2TMS derivative | Alkaloid | 469 | 70 | 0.5 |
| 48 | 3049 | Tris(4-bromophenyl) amine | Amine | 479 | 86 | 0.2 |
| 49 | 3228 | Catechin (2R-E)-, 5TMS derivative | Flavonoid | 650 | 72 | 0.9 |
| 50 | 3343 | Spirosol-5-en-3-ol, 28-acetyl-, acetate, (3.β.,22.α.,25R)- | Alcohol | 497 | 96 | 6.6 |
| 51 | 3401 | Tetratriacontane | Alkane | 478 | 96 | 0.5 |
| 52 | 3410 | Stigmasta-3,5-dien-7-one | Sterol | 410 | 75 | 0.7 |
| 53 | 3600 | Hexatriacontane | Alkane | 506 | 95 | 2.8 |
| 54 | 3986 | Propanoic acid, 3,3′-thiobis-, ditetradecyl ester | Acid | 570 | 75 | 2.8 |
| Compound No. | RI | Identified Compounds | %Similarity | Area (%) |
|---|---|---|---|---|
| 1 | 930 | α-Thujene | 97 | 1.4 |
| 2 | 948 | α-Pinene | 97 | 0.8 |
| 3 | 952 | Camphene | 97 | 0.4 |
| 4 | 975 | Sabinen | 97 | 0.1 |
| 5 | 979 | β-Pinene | 98 | 0.3 |
| 6 | 991 | β-Myrcene | 96 | 1.6 |
| 7 | 1009 | α-Phellandrene | 94 | 0.3 |
| 8 | 1013 | δ-3-Carene | 95 | 0.1 |
| 9 | 1018 | α-terpinene | 97 | 1.5 |
| 10 | 1020 | o-Cymene | 97 | 11.8 |
| 11 | 1059 | p-Cineole | 96 | 1.8 |
| 12 | 1062 | γ-Terpinene | 97 | 10.9 |
| 13 | 1109 | 2-p-Menthen-1-ol | 96 | 1.0 |
| 14 | 1112 | Linalool | 97 | 1.3 |
| 15 | 1138 | Borneol | 97 | 1.0 |
| 16 | 1177 | 4-Terpineol | 96 | 0.4 |
| 17 | 1231 | p-Cymene | 96 | 7.6 |
| 18 | 1262 | Thymol | 97 | 41.9 |
| 19 | 1298 | carvacrol | 96 | 3.6 |
| 20 | 1464 | Caryophyllene | 98 | 1.2 |
| 21 | 1515 | Germacrene D | 93 | 0.7 |
| 22 | 1524 | δ-Cadinene | 92 | 0.1 |
| 23 | 1581 | Caryophyllene oxide | 94 | 0.3 |
| 24 | 1757 | Humulane-1,6-dien-3-ol | 93 | 0.2 |
| Protein/X Y Z | Ligand Name | Pubchem ID | Types of Bond | Score |
|---|---|---|---|---|
| FMK1 x = 27.4555 y = 1.5129 z = 40.778 | Carvacrol | 10364 | H bond pi-sigma pi-alyl | −6.4 |
| Thymol | 6989 | −6.3 | ||
| α-Thujene | 17868 | −5.7 | ||
| Hexatriacontane | 12412 | −6 | ||
| Nonacosane | 12409 | −5.9 | ||
| Palmitic acid (Hexadecenoic acid) | 985 | −5.1 | ||
| Tetratriacontane | 5282743 | −5.7 | ||
| Stigmasta-3,5-dien-7-one | 26519 | −5.8 | ||
| SET7 x = 47.3052 y = −15.6381 z = −5.1291 | α-Thujene | 17868 | Hbond carbon Hbond pi-sulfur pi-Alkyl | −5.6 |
| Carvacrol | 10364 | −6.1 | ||
| Thymol | 6989 | −6.9 | ||
| Hexatriacontane | 12412 | −6.5 | ||
| Nonacosane | 12409 | −5.9 | ||
| Palmitic acid | 985 | −5 | ||
| (Hexadecenoic acid) | 5282743 | −5.2 | ||
| Tetratriacontane | 26519 | −5.8 | ||
| Stigmasta-3,5-dien-7-one | 12444466 | −4.2 | ||
| SET12 x = 37.1282 y = 38.5316 z = 37.5226 | α-Thujene | 17868 | H bond carbonHbond pi-sulfur pi-donor Hydrogen | −3.6 |
| Carvacrol | 10364 | −4.1 | ||
| Thymol | 6989 | −4.1 | ||
| AreA x = 37.1282 y = 38.5316 z = 37.5226 | α-Thujene | 17868 | H bond carbonHbond pi-sulfur pi-donor Hydrogen | −3.6 |
| Carvacrol | 10364 | −4.1 | ||
| Thymol | 6989 | −4.1 | ||
| AreA x = 36.9175 y = −94.8871 z = 8.6668 | α-Thujene | 17868 | Hbond Pi-pi-T-shaped | 4.3 |
| Carvacrol | 10364 | −4.8 | ||
| Thymol | 6989 | −4.6 | ||
| MeaB x = 16.164 y = 0.1875 z = −2.9961 | Carvacrol | 10364 | carbon H pi-sigma pi-sulfur | −3.9 |
| Thymol | 6989 | −4.3 | ||
| α-Thujene | 17868 | −4.1 | ||
| Rho1 x =94.6544 y =35.8305 z = 26.0388 | α-Thujene | 17868 | Pi-pi-T-shaped pi-Alkyl | −5.2 |
| Carvacrol | 10364 | −5.5 | ||
| Thymol | 6989 | −6.5 | ||
| Hexatriacontane | 12412 | −5.8 | ||
| Nonacosane | 12409 | −5.4 | ||
| Palmitic acid | 985 | −5.2 | ||
| (Hexadecenoic acid) | 5282743 | −5.2 | ||
| Tetratriacontane | 26519 | −5.7 | ||
| Stigmasta-3,5-dien-7-one | 12444466 | −5.1 | ||
| MKK1,2 x = 61.2779 y = −19.0646 z = 15.7687 | α-Thujene | 17868 | Van der Waals Alkyl pi-Alkyl | −6.8 |
| Carvacrol | 10364 | −6.1 | ||
| Thymol | 6989 | −5.8 | ||
| SEG1 x = 6.2314 y = 35.6614 z =101.8374 | α-Thujene | 17868 | Conventional Hbond pi-sulfur pi-pi stacked | −4.1 |
| Carvacrol | 10364 | −4.9 | ||
| Thymol | 6989 | −5.2 | ||
| Hexatriacontane | 12412 | −5.1 | ||
| Nonacosane | 12409 | −5.4 | ||
| Palmitic acid | 985 | −5.1 | ||
| (Hexadecenoic acid) | 5282743 | −4.9 | ||
| Tetratriacontane | 26519 | −4.8 | ||
| Stigmasta-3,5-dien-7-one | 12444466 | −4.7 | ||
| XINR x = −0.4654 y = −1.4131 z = −3.89 | Thymol | 6989 | pi-donor H bond pi-Alkyl carbon H bond | −4.2 |
| α-Thujene | 17868 | −4.1 | ||
| PACC x = 5.5317 y = 8.243 z = 49.2927 | α-Thujene | 17868 | H bond pi-Alkyl pi-sigma | −4.2 |
| Carvacrol | 10364 | −5.2 | ||
| Thymol | 6989 | −4.5 | ||
| Hog1 x = 26.713 y = 0.6519 z = 29.6776 | Carvacrol | 10364 | H bond pi-sigma pi-sulfur pi-Alkyl, Alkyl | −6.3 |
| Thymol | 6989 | −5.7 | ||
| α-Thujene | 17868 | −5.8 |
Publisher’s Note: MDPI stays neutral with regard to jurisdictional claims in published maps and institutional affiliations. |
© 2021 by the authors. Licensee MDPI, Basel, Switzerland. This article is an open access article distributed under the terms and conditions of the Creative Commons Attribution (CC BY) license (https://creativecommons.org/licenses/by/4.0/).
Share and Cite
Omar, H.S.; Abd El-Rahman, S.N.; AlGhannam, S.M.; Reyad, N.E.-H.A.; Sedeek, M.S. Antifungal Evaluation and Molecular Docking Studies of Olea europaea Leaf Extract, Thymus vulgaris and Boswellia carteri Essential Oil as Prospective Fungal Inhibitor Candidates. Molecules 2021, 26, 6118. https://doi.org/10.3390/molecules26206118
Omar HS, Abd El-Rahman SN, AlGhannam SM, Reyad NE-HA, Sedeek MS. Antifungal Evaluation and Molecular Docking Studies of Olea europaea Leaf Extract, Thymus vulgaris and Boswellia carteri Essential Oil as Prospective Fungal Inhibitor Candidates. Molecules. 2021; 26(20):6118. https://doi.org/10.3390/molecules26206118
Chicago/Turabian StyleOmar, Hanaa S., Soheir N. Abd El-Rahman, Sheikha M. AlGhannam, Nour El-Houda A. Reyad, and Mohamed S. Sedeek. 2021. "Antifungal Evaluation and Molecular Docking Studies of Olea europaea Leaf Extract, Thymus vulgaris and Boswellia carteri Essential Oil as Prospective Fungal Inhibitor Candidates" Molecules 26, no. 20: 6118. https://doi.org/10.3390/molecules26206118
APA StyleOmar, H. S., Abd El-Rahman, S. N., AlGhannam, S. M., Reyad, N. E.-H. A., & Sedeek, M. S. (2021). Antifungal Evaluation and Molecular Docking Studies of Olea europaea Leaf Extract, Thymus vulgaris and Boswellia carteri Essential Oil as Prospective Fungal Inhibitor Candidates. Molecules, 26(20), 6118. https://doi.org/10.3390/molecules26206118






